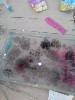
Изображение Изображение

11 декабря ребята из 4 «В» класса побывали в Музей книги Новосибирской государственной областной научной библиотеки. В рамках городского проекта «Арт-субботы» им удалось побывать на уникальном мастер-классе «Шуршащий мрамор» по созданию бумаги с индивидуальным рисунком с использованием технологии мраморирования (техника эбру).
Сегодня были раскрыты тайны непохожей на обычную живопись, а порой и кажущейся чудом техники рисования по водной глади – эбру. Рисование на воде – очень увлекательное и совершенно несложное занятие, которое отлично развивает фантазию и чувство цвета. Во время смешивания красок получились непредсказуемые орнаменты и рисунки, которые скорее напоминают узоры на природных минералах, либо оперение экзотических птиц, чем результат творчества.
Классный руководитель М.В. Золотова